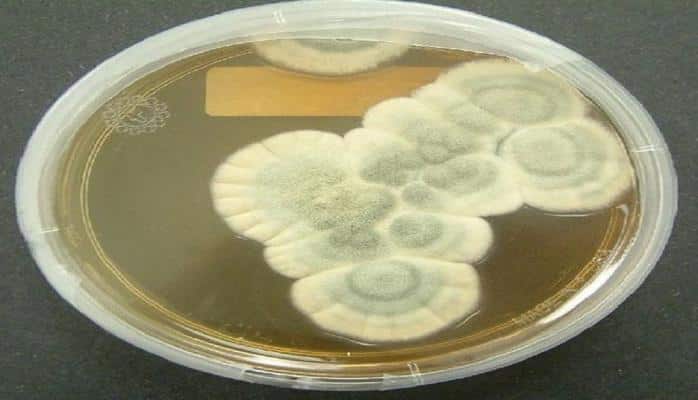

Təsadüfən edilən altı ixtira
Alimlər tədqiqat və təcrübəyə çox vaxt sərf edirlər və onlara yeni kəşflər etmək üçün xeyli güc və bacarıq tələb olunur.
Lakin mühüm bir kəşf bəzən alim və ya sadə bir insan tərəfindən tamamilə təsadüfən də edilir.
Aşağıda səhvən edilmiş 6 kəşf haqqında danışacağıq:
1. Кardiostimulyator

Qreytbetç soyadlı alim tamamilə təsadüf nəticəsində milyonlarla insanın həyatını xilas edən qurğu ixtira edib.
Alim insan ürəyinin ritmini qeyd etməyə kömək edən cihaz üzərində işləyirdi.
O, 1956-cı ildə Buffalo Universitetinin laboratoriyasında işləyən zaman səhvən başqa rezistoru bağlayır. Rezistorun yaratdığı elektrik impulsları insan qəlbinin döyüntüsünə çox bənzəyirdi.
Bunun nə qədər perspektivli olduğunu anlayan alim insan bədənində yerləşdirə bilmək üçün öz cihazını mümkün qədər kiçik etmək üzərində işləməyə başlayır.
Kiçik ölçüdə olan cihaz ilk dəfə 1958-ci ildə itlər üzərində test edilir. Daha sonra Qreytbetç bir çox insanın uzunömürlülüyü yolunda əhəmiyyətli bir addım olan ixtirasını patentləşdirir.
2. Qarğıdalı lopaları

Qarğıdalı lopalarının tarixi öz başlanğıcını XIX əsrdən götürür. Miçiqan ştatında “Batl-Krik” sanatoriyasının sahibləri, həkim Kelloq və onun qardaşı Vill Kit Kelloq qarğıdalı unundan hansısa yeməyi hazırlayırdılar, lakin onlar pansionun təxirəsalınmaz işləri üzrə təcili surətdə getməli olurlar.
Onlar qayıtdıqda isə qarğıdalı ununun bir qədər korlandığını görürlər. Buna baxmayaraq, onlar undan yemək hazırlamaq fikrindən vaz keçmirlər, lakin xəmir çürüyür, əvəzində isə lopa və toplar yaranır. Ruhdan düşən qardaşlar bu lopaları oda atırlar və məlum olur ki, onların bəziləri yüngül, bəziləri xoş xırtıldayan konsistensiyaya çevriliblər.
Sonradan bu lopalar Kelloqun pasiyentlərinə yeni yemək kimi təklif edilir. Süd və zefirlə süfrəyə verilən lopalar tezliklə məşhurlaşır. Vill Kit Kelloq lopalara şəkər əlavə edərək, onların dadını geniş auditoriya üçün daha münasib edir.
Beləliklə, 1894-cü ildə orijinal qarğıdalı lopaları amerikalı həkim Con Harvi Kelloq tərəfindən patentləşdirilir. 1906-cı ildə Kelloqlar yeni qida növünün kütləvi istehsalına başlayırlar və öz şirkətlərini yaradırlar.
3. Mikrodalğalı soba

Təəccüblü olsa da, mikrodalğalı soba, demək olar ki, təsadüfən icad edilib. İxtiraçı-mühəndis Persi Spenserin böyük kəşfini necə etdiyinə dair əfsanələr gəzir.
Bəzi mənbələr iddia edirlər ki, o, işləyən maqnetronun yanından keçərkən, cibində konfetlərin necə əridiyini hiss edib. Başqa bir versiyaya görə, Spenser maqnetronda sendviç qızdırırdı. Hər halda, ona qədər heç kim yemək üçün yüksəktezlikli şüadan istifadə etməmişdi.
Əvvəlki xidmətlərinə baxmayaraq, 1940-cı illərdə “Raytheon” şirkətində işləyərkən etdiyi ixtira Spenseri bütün dünyaya tanıdır.
Mikrodalğalı sobaya patent 1946-cı ildə verilir, “Radarange” adlı ilk soba isə 1947-ci ildə işıq üzü görür.
Bu, olduqca iri sobalar idi. Demək olar, insan boyu hündürlükdə, 300 kq ağırlığında olan bu sobalar müasir dövrdə istifadə etdiklərimizdən çox fərqlənirdi. Onların qiyməti də olduqca yüksək - 3 min dollara yaxın idi.
Yalnız 1960-cı illərdə əlverişli qiymətlərlə (təxminən, 500 dollar) və nisbətən kiçik ölçülü məişət mikrodalğalı sobalarının kütləvi istehsalı başlanılır.
4. Kevlar

Kevlar “DuPont” şirkəti tərəfindən istehsal olunan lifdir. Kevlar olduqca davamlılığı ilə seçilir. O, ilk dəfə 1964-cü ildə “DuPont” firmasının əməkdaşı - amerikalı kimyaçı Stefani Kvolekin qrupu tərəfindən əldə olunub. Kevların istehsal texnologiyası 1965-ci ildə hazırlanıb, 1970-ci illərin əvvəllərindən isə sənaye istehsalına başlanılıb.
Materialın mexaniki xüsusiyyətləri onu fərdi zirehli müdafiə vasitələrinin - zirehli jiletlər və zirehli dəbilqələrin istehsalı üçün əlverişli edir.
1970-ci illərin ikinci yarısında aparılan tədqiqatlar göstərib ki, kevlar-29 markasının lifi və onun sonrakı modifikasiyaları çoxlaylı parça və plastik sədd şəklində istifadə zamanı enerjini udma sürəti və zərbəyə qarşı dözüm müddətinə görə ən yaxşı nəticə verir və bununla da bu kütlə həddində nisbətən yüksək gülləyəqarşı və qəlpəyəqarşı dayanıqlılıq göstəricilərinə malikdir.
“DuPont” şirkətində işləyən zaman Stefani Kvolek kevları ixtira edir. Belə ki, 1964-cü ildə onun qrupu neft defisiti gözləntiləri fonunda şinlərdə istifadə oluna biləcək yüngül, lakin möhkəm lif axtarmağa başlayr.
Alınan lif neylondan fərqli olaraq kövrək olmur. Laboratoriyanın rəhbəri və direktoru bu ixtiranın əhəmiyyətini anlayır. Polimerlər kimyasının bu yeni sahəsi sürətlə inkişaf etməyə başlayır. 1971-ci ildə isə müasir kevlar əldə olunur.
5. Penisillin
Tibbi praktikada antibiotiklərdən istifadə yüzlərlə insan həyatını xilas edib. Penisillinin kəşfi sayəsində insanlar ta XX əsrin əvvəllərinə qədər müalicəsi mümkün olmayan xəstəliklərdən yaxa qurtarıblar.
Penisillinin kəşfi alim-həkim Aleksandr Fleminqin adı ilə bağlıdır. O, Londonun müqəddəs Mariya xəstəxanasının laboratoriyasında professor idi. Onun elmi fəaliyyətinin əsas mövzusu stafilakokların inkişafı və xüsusiyyətləri idi. O, penisillini təsadüfən kəşf edir.
Fleminq səliqəliliyi ilə çox da seçilmirdi. O, bir dəfə iş stolunun üstündə içində bakteriya kulturaları olan yuyulmamış fincanı unudur. Bir neçə gündən sonra isə onun içində kif əmələ gəldiyini görür.
O, kifin ətrafındakı baktareyaların öldüyünə diqqət yetirir. Fleminq kifin ifraz etdiyi substansiyaya penisillin adı verir.
Alim çoxlu sayda təcrübələr apardıqdan sonra əmin olur iki, həmin maddə xəstəliklər yaradan müxtəlif növ bakteriyaları öldürür.
6. Kartof çipsi

Çipslərin Corc Kramın 24 avqust 1853-cü ildə Saratoqa Sprinqs kurortunda “Moon ' s Lake Lodge” hotelinin restoranında baş aşpaz işləyərkən təsadüfən kəşf etdiyi hesab olunur. Əfsanəyə görə, “Moon ' s Lake Lodge” restoranının firma reseptlərindən biri fri kartofu idi.
Bir dəfə şam yeməyində dəmir yolu maqnatı Kornelius Vanderbilt qızardılmış kartofu “çox qalın”olmağından şikayət edərək mətbəxə qaytarır. Baş aşpaz Kram maqnatı ələ salmaq qərarına gələrək kartofu, demək olar, kağız qalınlığında kəsərək qızardır.
Lakin maqnat və dostlarının yemək xoşuna gəlir. Reseptə "Saratoqa çipsləri" adı verilir. Bir müddət sonra çipslər restoranın ən məşhur firma yeməyinə çevrilir.
1860-cı ildə Kram öz restoranını açır (1890-cı ilə qədər işlədib). Onun hər bir stolunun üstündə çipslə dolu bir səbət qoyulur. Restoran tez bir zamanda istirahətə gələn zəngin amerikalıların sevimli məkanına çevrilir.
Kram çipsləri restorandan çıxarmağa icazə vermirdi, lakin resept çox sadə olduğu üçün əksər restoranlarda təklif olunmağa başlayır.























Şərhlər
Şərhləri göstər Şərhləri gizlət